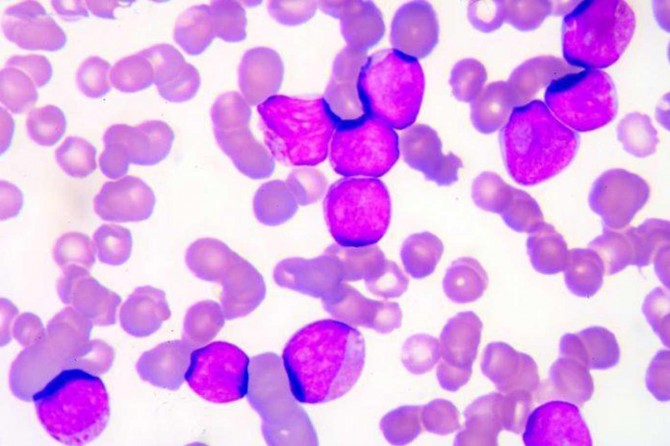

Kronik Miyeloid Lösemi hastaları doktor kontrolünde normal bir hayat sürebilir
Halk arasında kan kanseri olarak bilinen Kronik Miyeloid Lösemi (KML) hastaları, geliştirilen tedaviler ve doktorları ile tam uyum içerisinde çalıştıkları takdirde, normal bir hayat sürebiliyor.
Her yıl 22 Eylül’de tüm dünyada gerçekleştirilen etkinlikler ile dikkat çekilen KML hastalığı bazen hiçbir belirti olmaksızın rutin bir kontrol sırasında teşhis ediliyor. Bunun dışında halsizlik veya dalak büyümesi ve onun sebep olduğu karında şişkinlik, karın sol üst kısmında ele gelen bir şişlik gibi belirtilerden yola çıkarak yapılan incelemelerle hastalık ortaya çıkabiliyor.
Temelinde Ph kromozomu olarak bilinen bir genetik bozukluğun yattığı ve hedefe yönelik bir tedavi yönteminin kullanıldığı KML (Kronik Miyeloid Lösemi) hastalığı bir çeşit kan kanseri olarak tanımlanıyor. Oluşumunda sebep olarak pek çok faktör öne sürülmesine rağmen, yüksek doz ve uzun süreli maruz kalınan radyasyon dışında başka faktörlerle bir ilişki kurulamayan KML hastalığına yakalanma oranı yüz bin kişide bir olarak hesaplanıyor. Türkiye’de yılda yaklaşık 800 civarında kişinin hastalığa yakalandığı tahmin edilirken, uzmanlar 2000’li yılların başından itibaren yeni ilaçların kullanıma girmesiyle KML hastalarının çoğunun kronik fazda kalıp, normalde beklenen yaşam süresini yaşadığı belirtiyor.
22 Eylül "Uluslararası KML Günü" kapsamında KML hastalığı ile ilgili bilgi veren Ege Üniversitesi Tıp Fakültesi Hematoloji Bilim Dalı Başkanı Prof. Dr. Güray Saydam, hastalığın zemininde genetik bir bozukluğun olduğunu söylerken, bu bozukluğun insan kök hücresinde, 9 nolu kromozomdan kopan bir parça ile 22 nolu kromozomdan kopan bir parçanın yer değiştirmesiyle ortaya çıktığını belirtti.
Uzun zamandır KML ile ilgilenen otoritelerin, 9. kromozomu 9. ay yani Eylül ve 22. kromozomu da eylül ayının 22. günü olarak simgeleştirdirdiğini belirten Prof. Dr. Saydam, bu nedenle her yıl eylül ayının yani 9. ayın 22. gününde KML’yi hatırlatıcı etkinlikler düzenlendiğini vurguladı.
Hiçbir hastanın kendilerine "KML oldum!" diye gelmediğini ifade eden Saydam, "Bu hastalıkta dalak çok büyüdüğü için, karın bölgesini tamamen doldurabilir ve bundan dolayı karında şişkinlik ve erken doyma gibi bulgular olabilir. Ayrıca, bir kemik iliği hastalığı olduğu için kemiklerde ağrı; sistemik bir hastalık olduğu için ateş, kilo kaybı, halsizlik, sık ve tekrarlayan enfeksiyonlar, cilt ve mukozalarda kanamalar olabilir. Bu şikayetlerden bir ya da birkaçına sahip kişiler mutlaka KML’dir denemez. Gerekli laboratuvar testlerinin yapılması şarttır." dedi.
Prof. Dr. Saydam, tam bir hasta hikayesi ve fizik muayene sonrası; hemogram ve çevresel kan yayması, kemik iliği aspirasyon ve biyopsisi ve kemik iliği örneğinden ileri yöntem tetkiklerle özel kromozom tayini yapılması gerektiğini belirtti.
2000’li yıllardan önce tanı alan her hastanın kronik faz, hızlanmış faz ve blastik (kan kanseri) faz olmak üzere 3 aşamadan geçtiğini, ancak geçerli tek küratif tedavi metodu olan allojeneik kök hücre nakli uygulanamadığı takdirde her hastanın bu 3 aşamayı da yaşadığını ve sürecin maalesef kötü sonuçlandığını aktaran Prof. Dr. Güray Saydam, 2000’li yılların başından itibaren yeni ilaçların kullanıma girmesiyle, hastaların çoğunun kronik fazda kaldığını ve normalde beklenen yaşam süresini yaşayabildiğini belirtti.
Saydam, "Günümüzde dünyanın her yerinde, KML tanısı alan bir hastanın ilk tedavi seçeneğinin tirozin kinaz inhibitörleri adı verilen ilaçlar var. Halen ülkemiz dahil pek çok ülkede yeni tanı hastaların tedavisinde ruhsatlı olup aktif kullanılıyor. 2000’li yılların başında hedefe yönelik bu ilaçların FDA tarafından onaylanması sonrasında; KML’nin seyri tamamen değişmiş ve normal şartlarda ortalama 5 yıl yaşam süresi beklentisi varken, bugün bu süre normal insanlarla eşitlenmiştir." şeklinde konuştu.
Çok az bir hasta grubunda, allojeneik kök hücre naklinin hala bir çözüm olarak mevcut olduğunu aktaran Saydam, "Ancak bunun için özel şartlar gerekir. Hamilelik gibi özel durumlarda da farklı tedavi yöntemleri uygulanabilir. Bunun haricinde, kök hücre naklinin alternatif olabildiği nadir vakaları dışarıda tutarsak, günümüzde standart tedavi, hedefe yönelik tirozin kinaz inhibitörleri dediğimiz ilaçlarla sağlanabilmektedir." dedi.
KML tanılı hastaların doktorlarıyla tam uyum içinde çalışması, zamanında kontrollerini yaptırması ve ilaçlarını düzenli ve tam olarak kullanması durumunda normal sağlıklı insanlar gibi yaşadığını vurgulayan Saydam, doktorları ile uyumlu bir şekilde tedavi sürecini yürüten KML hastalarının seyahat etmelerinde, çalışmalarında, evlenmelerinde, ya da spor yapabilmelerinde sakınca olmadığını ifade etti.
Kronik ve ömür boyu sürecek bir hastalık olduğu ve her gün ilaç almayı gerektirdiği için, hastalarda bir süre sonra bıkkınlık ve alışmışlık bulguları ortaya çıktığını söyleyen Saydam, "Bunun sonucu olarak hastalar ilaçlarını tam almıyor veya kontrollerini aksatmaya başlıyor. Unutulmaması gereken nokta şudur ki; bu bir kanserdir ve doğru dürüst takip ve tedavi edilmediği durumlarda ölümcül olabilecek bir kan kanseridir. Bundan dolayı, lütfen zamanında kontrollerinizi yaptırın ve ilacınızı zamanında ve eksiksiz kullanın." çağrısında bulundu.
İLKHA









Türkçe karakter kullanılmayan ve büyük harflerle yazılmış yorumlar onaylanmamaktadır.